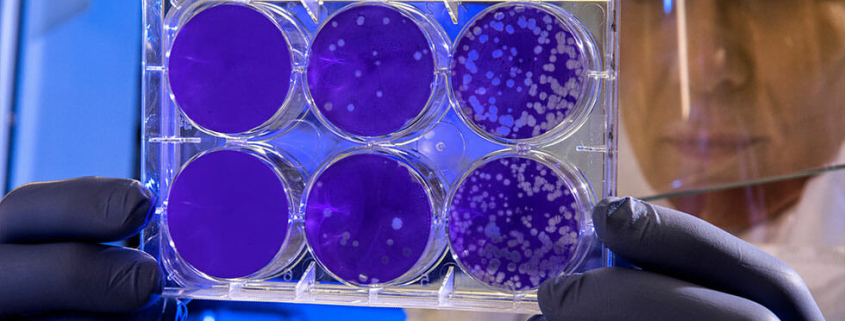
coronavirus and pets

Coronavirus & Pets
With the current outbreak of COVID-19 or Coronavirus, many pet owners are fearful that this virus could affect their pets. Pet Insurance Australia takes a look at the facts and investigates if pets can actually spread this virus.
“It’s very concerning to hear of reports that some companion animals’ welfare is at stake from false information floating around in regard to companion animals and their ability to spread this virus,” Nadia Crighton from Pet Insurance Australia says. “To date, the spread of COVID-19 is from human to human only and there is no evidence that companion animals spread the disease and very limited evidence that pets can even be infected with it.*”
The World Organisation for Animal Health and WSAVA Global Veterinary Community and One Health Committees have been busy investigating, monitoring and suggesting good advice when it comes to our companion animals around this outbreak.
“The good news is that we have many top scientists and veterinary specialists from around the world monitoring this,” Nadia Crighton from Pet Insurance Australia says.
WSAVA also states that the current spread of COVID-19 is a result of human to human transmission. “To date, there is no evidence that companion animals can spread the disease. Therefore, there is no justification in taking measures against companion animals which may compromise their welfare.”
PIA is urging all pet owners to be sensible during this time and keep updated with the facts. If you are concerned about the welfare of any companion animal to report it as quickly as possible.
“Some people are getting rather erratic and behaving in very unusual ways since the outbreak,” Crighton says. “Sadly this could seriously affect the welfare and safety of some of our companion animals.”
PIA suggests only sourcing information from reputable websites and not social media or unreliable/fake news.
“Look at the research and educate yourself on this topic,” Crighton says. “The leaders in this research are WSAVA, The World Organisation for Animal Health, The Global Veterinary Community, One Health Committees and Centres for Disease Control and Prevention,” Crighton says. “Trust in the experts on this topic and keep yourself updated with the facts.”
WHAT IF I GET SICK?
There are some guidelines if you do catch COVID-19 in regard to your companion animals.
“There are some recommendations from the Centres for Disease Control and Prevention that if you are sick or become sick with COVID-19 to avoid contact with your pet, as you would other people,” Crighton says. “This is more of a precautionary move until more information is known about the virus**.”
WSAVA advises to ask a family member or friend to care for your pet if you do become sick, or if unable to do so, practice very good hygiene.
“Basic things like ensuring you wash your hands when handling your pets food or supplies and avoiding kissing, licking or sharing food,” Crighton says. “Also consider utilising a face mask for yourself.”
“Most importantly stay calm and ensure your pet is well looked after and be prepared that if you do get sick, you have everything your pet needs,” Crighton says. “Having extra pet food and pet medications on hand is always a good idea, particularly coming into the flu season.”
**https://www.cdc.gov/coronavirus/2019-ncov/faq.html#2019-nCoV-and-animals